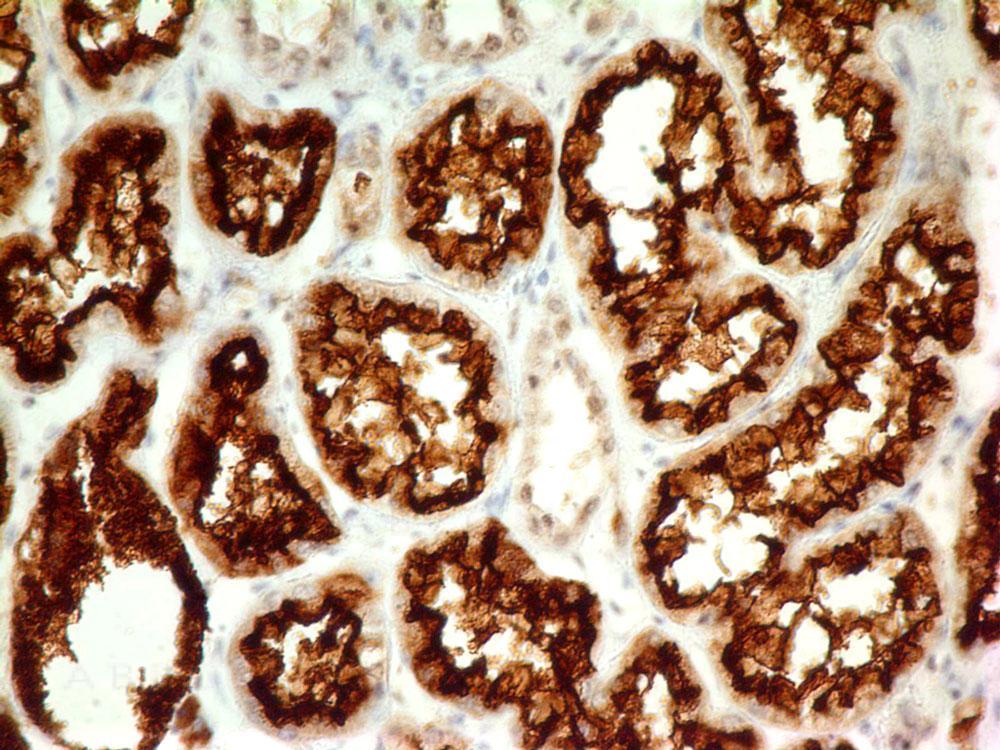

Monoclonal Antibody to CD10 (Clone: ABM4A52)
Fig-1: Immunohistochemical analysis of CD10 in human Renal CellCarcinoma tissue using CD10 antibody (Clone: ABM4A52) at 5 µg/ml.
Roll over image to zoom in
Shipping Info:
Order now and get it on Tuesday August 19, 2025
Same day delivery FREE on San Diego area orders placed by 1.00 PM
Format : | Purified |
Amount : | 100 µg |
Isotype : | Mouse IgG2b Kappa |
Purification : | Protein G Chromatography |
Content : | 25 µg in 50 µl/100 µg in 200 µl PBS containing 0.05% BSA and 0.05% sodium azide. Sodium azide is highly toxic. |
Storage condition : | Store the antibody at 4°C; stable for 6 months. For long-term storage; store at -20°C. Avoid repeated freeze and thaw cycles. |
CD10, also known as membrane metalloendopeptidase, neutral endopeptidase, neprilysin and common acute lymphoblastic leukaemia antigen (CALLA), is a zinc-dependent metalloendoprotease that cleaves signaling peptides. It is widely expressed in various normal tissues and in epithelial, stromal or both components of various malignancies. CD10 is a marker for intestinal epithelial brush border. It is also present in normal bile ducts and gallbladder epithelia but is absent in cholangiocarcinomas. It is con-sidered as the prototype of this family of membrane-bound, zinc-dependent endopeptidases, which regulate the physiological action of various peptides by lowering their extracellular concentration available for receptor binding. CD10 is also known to be an amyloid b-peptide (Ab) degrading enzyme. Polymorphisms in the CD10 gene increase the risk for Alzheimers disease. Outside the nervous system, it is present on the surface of neutrophils and regulates their activation by degradation of inflammatory peptides.
Western blot analysis: 0.5-1 µg/ml; Immunohistochemical analysis: 5-10 µg/ml, FACS: 0.5-2 µg/10^6 cells
For Research Use Only. Not for use in diagnostic/therapeutics procedures.
Subcellular location: | Cell membrane |
Post transnational modification: | Glycosylation at Asn-628 is necessary both for surface expression and neutral endopeptidase activity. |
BioGrid: | 110455. 102 interactions. |
There are currently no product reviews
|